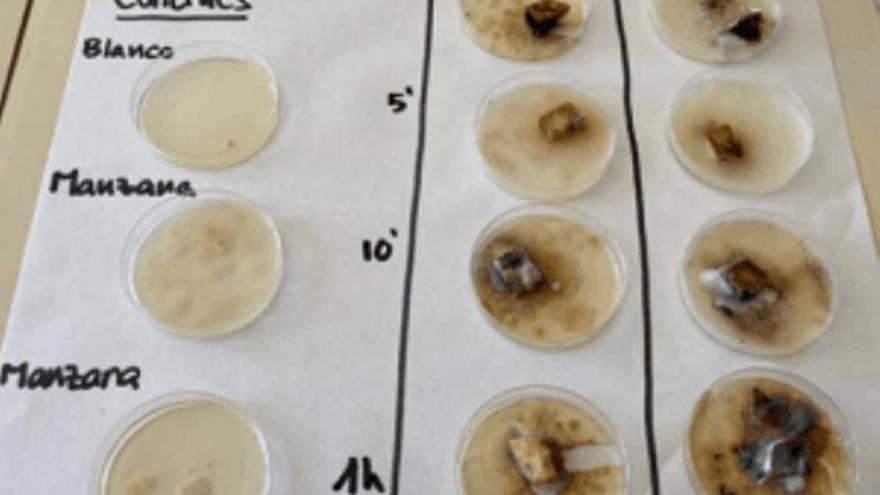

Cazadores de mitos: los estudiantes españoles que investigan desmontando bulos

Según datos extraídos de la última encuesta de Percepción Social de la Ciencia y la Tecnología en España, elaborada por la Fundación Española para la Ciencia y Tecnología (FECYT), casi 4 de cada 5 jóvenes de entre 15 y 24 años (79,6 %) acude a internet para informarse sobre temas de ciencia y salud. Sin embargo, este medio no siempre alberga buenas intenciones y puede generar confusión, falsedades y desinformación, sobre todo entre quienes disponen de menos recursos para no caer en engaños.
Con el propósito de dotar a la juventud de herramientas y conocimiento que les permita ser menos vulnerables a la influencia de falsas creencias, la fundación puso en marcha a comienzos del curso lectivo “Cazadores de mitos”, un proyecto destinado a alumnos de 2º y 3º de la ESO cuyo objetivo ha sido comprobar la veracidad de mitos o creencias cotidianas a través del método científico.
Una vez inscritos, los adolescentes han diseñado sus propias investigaciones para saber si, por ejemplo, una moneda que caiga desde un rascacielos puede matarnos, qué hay de verdad en la astrología o si podemos engañar a la probabilidad para ganar en juegos de azar.
La ciencia como herramienta para aprender y divertirse
“Antes tenía un concepto de ciencia diferente, como que era más aburrida. Ahora me he dado cuenta de que es divertida”, comenta a SINC una alumna de secundaria del IES Bernat de Sarriá, en Benidorm (Alicante). “A mí me gustaría estudiar microbiología, biotecnología o biofarmacéutica. Ya me gustaba esta rama, pero con este proyecto me he convencido aun más”, comenta otro.
Ambos, miembros de los equipos Las cien y Vitateam, han sido seleccionados como dos de los mejores retos en sus respectivos mitos. “Hemos demostrado que las vitaminas del zumo recién exprimido no se van tan rápidamente con el tiempo”, afirma una compañera tras concluir su investigación. Otra aconseja: “Si se te cae al suelo el bocadillo es mejor que no te lo comas, ya que puedes tener dolor de estómago o acabar en el baño durante toda la noche”, explica mientras ríe junto a sus compañeros.
Muestras de manzana contaminada obtenidas por el grupo Las Cien, del IES Bernat de Sarriá.
Para desarrollar ambas investigaciones, los jóvenes acudieron al centro varios miércoles por las tardes, fuera del horario lectivo. Sus resultados los han expuesto en sendos pósters, aunque Laura García-España, una de sus profesoras, aclara a SINC que tuvieron algunas dificultades a la hora de diseñar y plasmar el trabajo sobre el papel.
“A medida que han ido descubriendo la ciencia, han ido involucrándose más. Les ha costado un poco la parte de la comunicación; llevar a cabo un experimento y no poder comunicarlo al mundo es casi lo mismo que no haberlo hecho”, detalla García-España.
Enrique Megía: Si tú explicas en clase “diseño de la experimentación”, es una frase que ellos memorizan. Pero cuando aquí hemos estado viendo cómo medir las vitaminas o qué pasos tenemos que dar... es una muy buena forma de aprender
Aun así, los chicos y chicas creen que ha sido una gran oportunidad para aprender ciencia de manera práctica. “Te enseña las etapas del método científico. Si te las preguntan en un examen, ya te las sabes porque ya las has hecho. Además, estás con tus compañeros, te lo pasas bien”, opina una joven.
“La sensación que tenemos es que la posibilidad de enseñar los contenidos que tenemos en el curso, de manera contextualizada, donde ellos ven una aplicación directa del método científico, es muy interesante. Si tú explicas en clase 'diseño de la experimentación', es una frase que ellos memorizan. Pero cuando aquí hemos estado viendo cómo medir las vitaminas o qué pasos tenemos que dar... es una muy buena forma de aprender”, concluye Enrique Megía, otro profesor involucrado en el proyecto.
Cualquiera puede hacer ciencia si se lo propone
El caso del IES Valle del Ebro, en Tudela (Navarra), sorprendió gratamente al jurado del certamen. La buena acogida del proyecto entre los estudiantes propició que tuvieran que repartir la investigación entre varios grupos de dos clases, con una implicación de 41 alumnos.
“Hubo un interés tan grande, con tantas hipótesis, que decidimos involucrar a dos clases enteras. Dentro de cada clase, hicimos subgrupos y cada grupo emitió una hipótesis diferente”, expresa a SINC Idoya Lacosta, profesora del instituto y tutora de los grupos Myth busters 1, 2, 3 y 4.

Los alumnos del IES Valle del Ebro reflejaron con palabras lo que había supuesto para ellos el proyecto.
“En principio nuestro mito consistía —al igual que el centro anterior— en saber si la vitamina del zumo permanecía estable con el tiempo. No obstante, uno de los grupos analizó la estabilidad de las vitaminas con el paso del tiempo; otro averiguó si dependía de la radiación ultravioleta; otro, si sufría una reacción de oxidación con el aire, otro, la temperatura...” enumera Lacosta.
Tras comentar el resultado del proyecto con sus alumnos, esta profesora considera que los jóvenes han aprendido varias cosas más allá del jugo de fruta y sus nutrientes, como que los científicos no necesariamente son hombres de avanzada edad o muy listos.
Idoya Lacosta: Si ellos aplican el método, pueden hacer investigación. Es decir, que el científico no es una persona extraña, diferente o más lista, sino que aplica el método científico
“Les hemos enseñado que ellos mismos pueden ser científicos. Es decir, que el científico no es una persona extraña, diferente o más lista, sino que aplica el método científico. Si ellos aplican el método, pueden hacer investigación”, explica la docente.
“También —añade— han aprendido que la investigación es un proceso colectivo, compuesta por líneas de investigación diferentes que se ponen en común. Siempre les hablamos de Newton, de Einstein u otras singularidades, pero no es la realidad”.
Nieve, plástico y nevacionistas
Para los alumnos del IES Modesto Navarro, en La Solana (Ciudad Real), la borrasca Filomena que sacudió al país en enero no fue solamente un fenómeno extraordinario, sino también la oportunidad de hacer ciencia y desmentir bulos que tenían lugar en directo y que se difundían a través de las redes sociales. En su caso, participaron en la categoría de temática libre y fueron calificados como uno de los dos mejores.
“Un día vimos el vídeo que circulaba por WhatsApp de la señora que quemaba la nieve con un mechero y decía que tenía plástico porque no goteaba y se ennegrecía. Entonces lo tuvimos claro”, recuerda a SINC una de las alumnas involucradas en el proyecto ¿Está nevando plástico?, del equipo Modesto.
Ha sido muy entretenido ver cómo podías trabajar de “científico” y ver cómo se hacen las cosas en un laboratorio, aunque nos quedaremos con la experiencia de pasarlo bien y de hacerlo juntos
Acordado el tema, los jóvenes acudían al centro los viernes por la tarde con hielo picado que recogían del suelo. Después, lo compactaban en diferentes formas, densidades y tamaños y trataban de replicar el experimento de aquella señora. Tras exponer la nieve a distintas llamas, procedente de diferentes fuentes, los alumnos concluyeron que el hollín negro que resultaba de la combustión no se debía a que el hielo contuviera plástico, sino al propio gas que contiene el mechero.

Con este y otros ingeniosos experimentos, los alumnos del IES Modesto Navarro desmintieron el bulo de la nieve de plástico.
“Lo más divertido ha sido diseñar cómo hacer el experimento, aunque plasmar los datos sobre el papel no tanto”, opina una alumna. “Ha sido muy entretenido ver cómo podías trabajar de científico y ver cómo se hacen las cosas en un laboratorio”, considera otro. Aunque la mayoría coincide: “Nos quedaremos con la experiencia de pasarlo bien, de hacerlo juntos”.
De la preocupación a la acción
Uno de los mitos más extendidos, y probablemente uno de los más arriesgados para ser contrastados por alumnos de secundaria, es el que lleva a negacionistas a desconfiar del cambio climático. Concienciados con el problema que supone para el planeta, los estudiantes del IES Ximén d'Urrea, en Castellón, decidieron llevar a cabo su proyecto.

Como auténticos científicos, los alumnos del IES Ximén d'Urrea realizaban experimentos sobre el cambio climático
“Hacer los experimentos nos ha costado unas doce sesiones de una hora en el laboratorio, pero hasta que llegamos al punto de cómo hacer el experimento y de que saliera bien, así como analizar los datos y tener conclusiones, ha ocupado mucho más tiempo dentro del laboratorio y fuera de clase”, explica a SINC una de las jóvenes del equipo Ximén.
Mediante distintos experimentos con CO2, fueron capaces de medir alteraciones en la temperatura, acidez o volumen en agua salada. “Hemos aprendido que el cambio climático es real, que se debe a las actividades humanas y nos afecta a todos los habitantes de la Tierra. Por eso tenemos que intentar que no vaya a peor”, afirma otro compañero del proyecto.
Mercedes Martínez: Ha sido una experiencia genial y creo que ha posibilitado que estudiantes de secundaria de localidades pequeñas, alejadas de los centros de divulgación científica, puedan demostrar que también ellos y ellas pueden y les interesa hacer ciencia
Sin embargo, el experimento en sí no supuso la mayor dificultad, sino que el mayor inconveniente fue el propio de vivir en zonas alejadas a las grandes urbes, sin las comodidades propias de una buena red de transportes. “Vivimos en dos pequeños pueblos distintos del interior de la provincia de Castellón, Llucena y Costur, mientras que el instituto está en L’Alcora. Esto lo complicó un poco todo. Hemos tenido que usar mucho el WhatsApp, el correo electrónico y la plataforma educativa del centro”, detalla otra de las integrantes.
“Convencerles fue muy sencillo, ya que no se les había dado una oportunidad así desde ninguna asignatura y no dudaron un segundo en participar en el proyecto Cazadores de Mitos. Ha sido una experiencia genial y creo que ha posibilitado que estudiantes de secundaria de localidades pequeñas, alejadas de los centros de divulgación científica como instituciones y museos, puedan demostrar que también ellos y ellas pueden y les interesa hacer ciencia”, considera Mercedes Martínez, su profesora.



